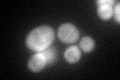

View description
Subunit of Elongator complex, which is required for modification of wobble nucleosides in tRNA; target of Kluyveromyces lactis zymocin
Localization:
Intensity:
Fold change:
Significance:
-
C’ GFP library in SD

cytosol59.94 -
N' NOP1pr-GFP in SD

cytosol44.1783 -
N' TEF2pr-mCherry in SD

cytosol32.0328 -
N' NATIVEpr-GFP in SD

below threshold30.5411 -
N' TEF2pr-VC and Cyto-VN in SD

below threshold28.282 -
C’ GFP library in SD+DTT
cytosol41.410.69No -
C’ GFP library in SD+H2O2

cytosol58.180.97No -
C’ GFP library in Starvation Media

cytosol27.010.45No -
C’ GFP library on the background of Pup2-DaMP

cytosol -
C’ GFP library on the background of CCT mutant

cytosol55.91970.932835No
